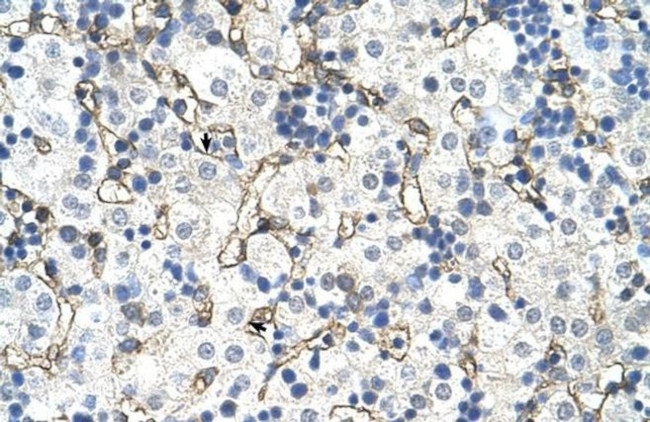

Search
Invitrogen
SLC39A5 Polyclonal Antibody
{{$productOrderCtrl.translations['antibody.pdp.commerceCard.promotion.promotions']}}
{{$productOrderCtrl.translations['antibody.pdp.commerceCard.promotion.viewpromo']}}
{{$productOrderCtrl.translations['antibody.pdp.commerceCard.promotion.promocode']}}: {{promo.promoCode}} {{promo.promoTitle}} {{promo.promoDescription}}. {{$productOrderCtrl.translations['antibody.pdp.commerceCard.promotion.learnmore']}}


Please note: We are reviewing Western blot images included in the antibody testing data in our catalog, including those provided by third parties. Unless expressly labeled or annotated as “raw-unedited”, Western blot images included in the antibody testing data in our catalog may have been edited, optimized or otherwise adjusted for presentation.
产品信息
PA5-42522
种属反应
宿主/亚型
分类
类型
抗原
偶联物
形式
浓度
规格
纯化类型
保存液
内含物
保存条件
运输条件
RRID
产品详细信息
Peptide sequence: MGSPVSHLLA GFCVWVVLGW VGGSVPNLGP AEQEQNHYLA QLFGLYGENG
Sequence homology: Cow: 86%; Dog: 93%; Guinea Pig: 93%; Horse: 86%; Human: 100%; Mouse: 100%; Rabbit: 100%; Rat: 100%
靶标信息
The zinc transporter ZIP5, also known as SLC39A5, is a member of a family of divalent ion transporters. Zinc is an essential ion for cells and plays significant roles in the growth, development, and differentiation. ZIP5 is closely related to ZIP4, and is found in many of the same tissues, including intestine, pancreas, liver, and kidney, but unlike ZIP4, ZIP5 localizes to the basolateral membrane in kidney cells and its activity is not downregulated by zinc repletion. Recent evidence suggests that ZIP4 and ZIP5 are reciprocally regulated, with translation of ZIP5 mRNA decreasing and ZIP5 protein being rapidly internalized and degraded in response to zinc deficiency.
仅用于科研。不用于诊断过程。未经明确授权不得转售。
篇参考文献 (0)
生物信息学
蛋白别名: MGC34778